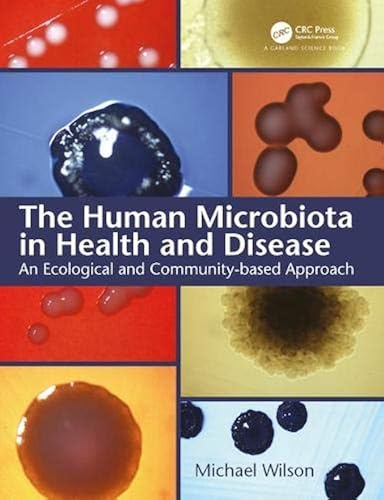
Download The Human Microbiota in Health and Disease: An Ecological and Community-based Approach PDF

[Télécharger] The Human Microbiota in Health and Disease: An Ecological and Community-based Approach de Michael Wilson Livres En Ligne
Télécharger The Human Microbiota in Health and Disease: An Ecological and Community-based Approach de Michael Wilson Livre eBook France
Télécharger "The Human Microbiota in Health and Disease: An Ecological and Community-based Approach" de Michael Wilson Livre eBook France
Auteur : Michael Wilson
Catégorie : Livres anglais et étrangers,Science,Biological Sciences
Broché : * pages
Éditeur : *
Langue : Français, Anglais
A human being consists of a mammalian component and a multiplicity of microbes, collectively referred to as the "microbiota" or "microbiome," with which it has a symbiotic relationship. The microbiota is comprised of a variety of communities, the composition of each being dependent on the body site it inhabits. This community variation arises because the numerous locations on a human being provide very different environments, each of which favors the establishment of a distinct microbial community. Each community consists of bacteria, fungi and viruses with, in some cases, archaea and/or protozoa. It is increasingly being recognized that the indigenous microbiota plays an important role in maintaining the health of its human host. However, changes in the overall composition of a microbial community at a body site, or an increase in the proportion of a particular species in that community, can result in disease or other adverse consequences for the host. The Human Microbiota in Health and Disease: An Ecological and Community-Based Approach describes the nature of the various communities inhabiting humans as well as the important roles they play in human health and disease. It discusses techniques used to determine microbial community composition and features a chapter devoted to the many factors that underlie this mammalian–microbe symbiosis. Uniquely, the book adopts an ecological approach to examining the microbial community’s composition at a particular body site and why certain factors can shift a community from a eubiotic to a dysbiotic state. The book is for undergraduates and postgraduates on courses with a module on the indigenous microbiota of humans. It will also be useful to scientists, clinicians, and others seeking information on the human microbiota and its role in health and disease.
Télécharger The Human Microbiota in Health and Disease: An Ecological and Community-based Approach de Michael Wilson Francais PDF
The Human Microbiota in Health and Disease An Ecological ~ The Human Microbiota in Health and Disease An Ecological and Community-Based Approach 29.10.2020 23:23 / Leave a Comment / lype The Human Microbiota in Health and Disease - ScienceDirect
Livres sur Google Play ~ Profitez de millions d'applications Android récentes, de jeux, de titres musicaux, de films, de séries, de livres, de magazines, et plus encore. À tout moment, où que vous soyez, sur tous vos appareils.
Home - PubMed - NCBI ~ PubMed comprises more than 26 million citations for biomedical literature from MEDLINE, life science journals, and online books. Citations may include links to full-text content from PubMed Central and publisher web sites.
Electronic library. Download books free. Finding books ~ Electronic library. Download books free. Finding books / Z-Library. Download books for free. Find books
bioRxiv - the preprint server for Biology ~ Welcome to the bioRxiv homepage. Search for this keyword . Advanced Search
My Health / Rebbeca J Donatelle / download ~ Livres; Télécharger un livre; Catégories; Les plus populaires; Fichiers récemment ajoutés; Z-Library Project; Top Z-Librarians; Blog ; Page d'accueil My Health. My Health Rebbeca J Donatelle. For students today, health is headline news. Whether it’s the latest cases of life-threatening E. coli infections from eating infected produce, a deadly Ebola epidemic threatening to kill millions .
CDC - National Health Initiatives, Strategies, and Action ~ Health IT. Connecting Health and Care for the Nation: A 10-Year Vision to Achieve an Interoperable Health IT Infrastructure pdf icon [PDF-607KB] external icon; Healthcare Quality. National Quality Strategy external icon; Heart Disease & Stroke. The Public Health Action Plan to Prevent Heart Disease and Stroke: Ten-Year Update pdf icon [PDF-2 .
Google Scholar ~ Google Scholar provides a simple way to broadly search for scholarly literature. Search across a wide variety of disciplines and sources: articles, theses, books, abstracts and court opinions.
Google Traduction ~ Ce service gratuit de Google traduit instantanément des mots, des expressions et des pages Web du français vers plus de 100 autres langues.
Google ~ Search the world's information, including webpages, images, videos and more. Google has many special features to help you find exactly what you're looking for.
Sci-Hub: removing barriers in the way of science ~ Such laws effectively slow down the development of science in human society. The Sci-Hub project, running from 5th September 2011, is challenging the status quo. At the moment, Sci-Hub provides access to hundreds of thousands research papers every day, effectively bypassing any paywalls and restrictions. If it were not for Sci-Hub – I wouldn't be able to do my thesis in Materials Science .
Google Translate ~ Google's free service instantly translates words, phrases, and web pages between English and over 100 other languages.
Outlook – free personal email and calendar from Microsoft ~ Expand your Outlook. We've developed a suite of premium Outlook features for people with advanced email and calendar needs. A Microsoft 365 subscription offers an ad-free interface, custom domains, enhanced security options, the full desktop version of Office, and 1 TB of cloud storage.
Accueil - Archive ouverte HAL ~ Archive ouverte HAL. L'archive ouverte pluridisciplinaire HAL, est destinée au dépôt et à la diffusion d'articles scientifiques de niveau recherche, publiés ou non, et de thèses, émanant des établissements d'enseignement et de recherche français ou étrangers, des laboratoires publics ou privés.. À l'attention du déposant. Le dépôt du texte intégral est effectué en accord avec .
ResearchGate / Find and share research ~ Access 130+ million publications and connect with 19+ million researchers. Join for free and gain visibility by uploading your research.
Garland Science – Livres, BD, Ebooks et prix des produits ~ The Human Microbiota in Health and Disease An Ecological and Community-based Approach - ebook (ePub) Mike Wilson (Auteur) A human being consists of a mammalian component and a multiplicity of microbes, collectively referred to as the "microbiota" or "microbiome," with which it has a symbiotic relationship.
The European Food Information Council : Food facts for ~ EUFIC is a non-profit organisation that provides clear, practical information on food and health, based on sound science. We believe in a world where people choose to live healthily because they know how to.
Livres PDF - Home / Facebook ~ Livres PDF. 3.8K likes. Livres PDF telecharger gratuit. Télécharger Le Temps des Tempêtes PDF. Télécharger Le Temps des Tempêtes EPUB, PDF Gratuitement, Télécharger Le Temps des Tempêtes PDF vos Ebook Gratuit français Gratuitement en format Epub, PDF, Kindle et utiliser votre lisseuse préférée pour les lire.
The Viral Storm: The Dawn of a New Pandemic Age / Nathan ~ Télécharger un livre; Catégories; Les plus populaires; Fichiers récemment ajoutés; Z-Library Project; Top Z-Librarians; Blog; Page d'accueil The Viral Storm: The Dawn of a New Pandemic Age. The Viral Storm: The Dawn of a New Pandemic Age Nathan Wolfe. Dynamic young Stanford biologist Nathan Wolfe reveals the surprising origins of the world's most deadly viruses, and how we can overcome .
Share and Discover Knowledge on SlideShare ~ Discover, Share, and Present presentations and infographics with the world’s largest professional content sharing community.
The BMJ: leading general medical journal. Research ~ Health inequalities must be tackled head on, warns Whitty in annual review of nation’s health . BMJ opinion Michael Marmot: Post covid-19, we must build back fairer. News Pulse oximetry may underestimate hypoxaemia in black patients, study finds. Editorial Asymptomatic transmission of covid-19. News Covid-19: Mass testing is inaccurate and gives false sense of security, minister admits. News .
Global plagues and the Global Fund: Challenges in the ~ Clearly, vertical disease control programs must be complemented by broader, horizontal approaches to health care and health infrastructure if AIDS, tuberculosis and malaria are to be controlled. By extension, policy makers must consider the broader socioeconomic inputs to health if outcomes are to be improved – an approach which may require higher-level political commitments and systemic .
Ecology - Wiley Online Library ~ Ecology publishes articles that report on the basic elements of ecological research.Emphasis is placed on concise, clear articles documenting important ecological phenomena. The journal publishes a broad array of research that includes a rapidly expanding envelope of subject matter, techniques, approaches, and concepts: paleoecology through present-day phenomena; evolutionary, population .
Linguee / Dictionnaire anglais-français (et autres langues) ~ Dictionnaire anglais-français avec des millions de phrases traduites en anglais-français. Moteur de recherche de traductions anglais-français.
Frontiers / Peer Reviewed Articles - Open Access Journals ~ Open-access publisher of peer-reviewed scientific articles across the entire spectrum of academia. Research network for academics to stay up-to-date with the latest scientific publications, events, blogs and news.
Comments
Post a Comment